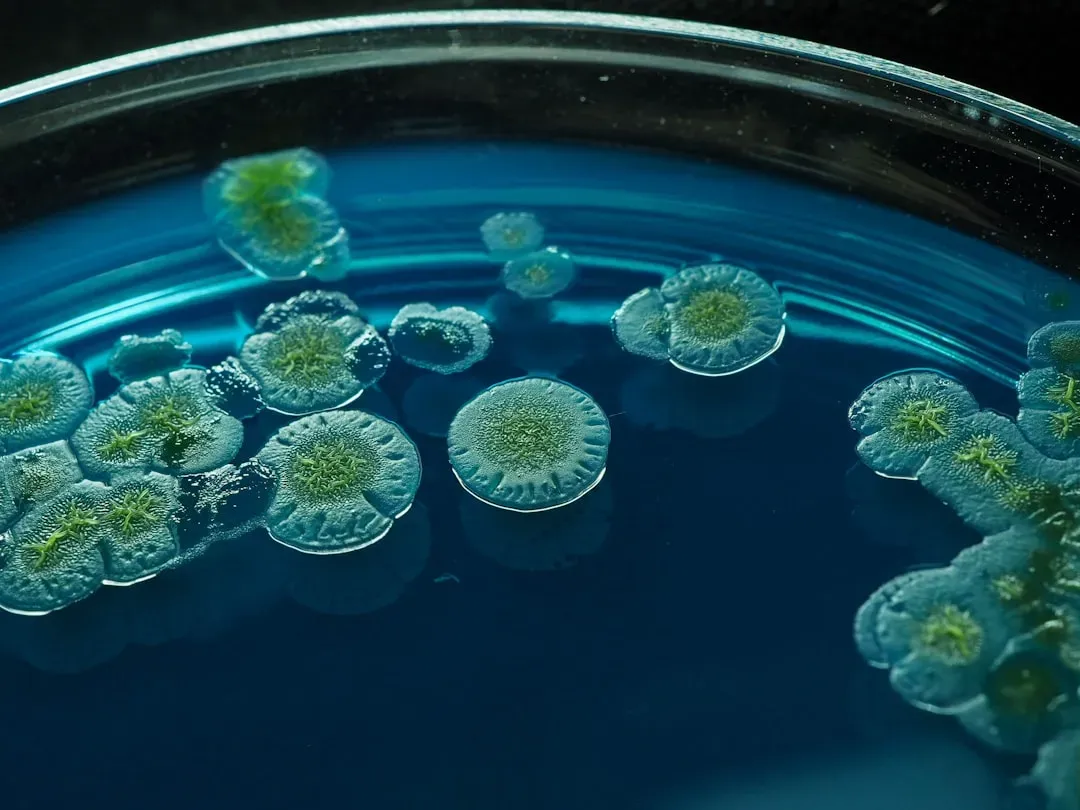
The Future: Harnessing Microbes for a Healthier Planet (Image Credits: Unsplash)

They’re invisible. They’re everywhere. They outnumber every other form of life on this planet by a margin so staggering it’s almost impossible to wrap your head around. We’re talking about microbes, the bacteria, fungi, viruses, archaea, and protozoa that silently power the biological machinery of Earth itself.
Most people associate microbes with sickness. That’s honestly a bit like hearing the word “fire” and only thinking about destruction. The reality is far more complex, far more interesting, and in many ways, genuinely humbling. From the soil beneath your feet to the lining of your gut, microbes are running the show in ways science is only beginning to fully appreciate. Let’s dive in.
The Invisible Majority That Runs the World

Here’s something that stopped me in my tracks when I first learned it: scientists estimate there are roughly ten to the power of thirty bacteria on Earth. That number is so large it makes the total count of stars in the observable universe look modest by comparison. Microbes are not just passengers on this planet. They are the foundation.
These organisms colonized Earth roughly three and a half billion years ago, long before plants, animals, or anything we’d recognize as life today. They essentially built the conditions that allowed complex life to evolve, including the oxygen-rich atmosphere we breathe. Without microbes doing their work for billions of years before us, we simply would not exist.
Life on Earth, in a very real sense, is a microbial story. Everything else, including us, is a late addition to a world they shaped and continue to maintain.
Microbes as the Architects of Healthy Soil

Soil looks simple. Most people think of it as just “dirt.” Yet a single teaspoon of healthy soil can contain more microorganisms than there are people on Earth. Bacteria, fungi, nematodes, and archaea work together in an extraordinarily complex underground ecosystem that determines whether plants live or die.
Microbes decompose dead organic matter, releasing nutrients back into the soil in forms that plants can actually absorb. Nitrogen-fixing bacteria, for instance, take atmospheric nitrogen and convert it into compounds that feed crops. Without this process, modern agriculture as we know it would collapse.
Let’s be real: every vegetable you’ve ever eaten owes its existence to microbial activity happening underground. The soil food web is one of the most underappreciated systems in all of ecology.
The Ocean’s Microbial Engine

Oceans cover more than two thirds of Earth’s surface, and they are teeming with microbial life in quantities that boggle the mind. Marine microorganisms, particularly cyanobacteria and phytoplankton, are responsible for producing roughly half of all the oxygen in our atmosphere. Half. Every other breath you take is essentially a gift from ocean microbes.
These tiny organisms also play a critical role in the carbon cycle. They absorb enormous quantities of carbon dioxide from the atmosphere through photosynthesis, helping regulate Earth’s climate in ways that no human technology has yet come close to replicating. When marine microbial communities are disrupted by pollution or ocean acidification, the downstream consequences for the entire planet are severe.
It’s hard to say for sure just how much we rely on these systems until you imagine them failing. The result would be catastrophic, not slowly, but fast.
Microbes Inside Us: The Human Microbiome

Your body is not entirely your own. Inside your gut alone, there are trillions of microbial cells, representing thousands of distinct species. This community, collectively known as the gut microbiome, influences digestion, immune function, mental health, and even how effectively your body responds to medications.
I think one of the most surprising revelations in modern medicine over the past couple of decades has been just how deeply our health is intertwined with our microbial passengers. Research has linked imbalances in the gut microbiome to conditions ranging from inflammatory bowel disease and obesity to anxiety and depression. The gut-brain axis, the communication network between your microbiome and your brain, is a genuinely fascinating frontier in neuroscience.
Think of your gut microbiome as an internal ecosystem. When it’s thriving and diverse, so are you. When it’s impoverished, your whole system feels it.
How Microbes Protect Us From Disease

One of the most counterintuitive things about microbes is that they protect us from other microbes. Beneficial bacteria that colonize your skin, mouth, gut, and respiratory tract occupy space and consume resources, essentially outcompeting harmful pathogens before they can take hold. This is sometimes called colonization resistance, and it’s a genuinely elegant biological defense system.
The widespread overuse of antibiotics has highlighted just how fragile this balance can be. Antibiotics don’t discriminate between harmful and helpful bacteria. After a course of antibiotics, the diversity of your gut microbiome can take months, sometimes longer, to recover. During that window, you’re actually more vulnerable to infections like Clostridioides difficile, a dangerous pathogen that thrives when the normal microbial landscape is disrupted.
Your microbiome is effectively a trained security team. Removing them carelessly leaves the doors wide open.
Microbial Roles in the Nutrient Cycles That Sustain Life

Every major nutrient cycle on Earth, including the carbon, nitrogen, sulfur, and phosphorus cycles, depends fundamentally on microbial activity. Without bacteria and archaea processing these elements, nutrients would accumulate in unusable forms, ecosystems would collapse, and the chemistry of the entire biosphere would unravel. This is not a minor background function. It is the engine of life itself.
Nitrogen cycling is a perfect illustration. Atmospheric nitrogen makes up nearly four fifths of the air we breathe, yet plants cannot use it directly. Specialized bacteria transform it into ammonia and nitrates through fixation, then other microbes later convert it back to atmospheric nitrogen through denitrification, completing the loop. This elegant microbial choreography happens constantly, invisibly, and on a planetary scale.
No engineer has ever designed a system this efficient, this self-sustaining, or this essential to life.
Microbes in Extreme Environments: The Boundary Pushers

Here’s where things get genuinely fascinating. Some microbes, known as extremophiles, thrive in conditions that would instantly destroy most living things. Boiling hydrothermal vents on the ocean floor, frozen Antarctic ice, highly acidic volcanic lakes, hypersaline environments like the Dead Sea. These organisms redefine what it means to be alive.
Extremophiles have dramatically expanded our understanding of where life can exist, not just on Earth but potentially elsewhere in the solar system. Scientists studying the icy moons of Jupiter and Saturn, places like Europa and Enceladus, often cite extremophilic microbes as evidence that life might persist in environments once considered completely inhospitable. It’s a humbling thought.
These microscopic boundary pushers remind us that life, given even the most unlikely circumstances, tends to find a way.
The Role of Microbes in Food and Fermentation

Long before anyone understood what microbes actually were, humans had already figured out how to use them. Fermentation, the microbial transformation of sugars into acids, gases, and alcohols, has been used for thousands of years to produce bread, beer, wine, cheese, yogurt, kimchi, and countless other foods. Every culture on Earth has a fermented food tradition. Every single one.
What’s remarkable is that these traditional fermented foods also happen to be incredibly beneficial for the gut microbiome. The live cultures in a good yogurt or a naturally fermented sauerkraut introduce beneficial bacterial strains into your digestive system. Honestly, our ancestors stumbled onto probiotic therapy long before modern science had a name for it.
Fermentation is essentially one of humanity’s oldest and most delicious partnerships with the microbial world.
Threats to Microbial Diversity and Why It Matters

Just as biodiversity among plants and animals is critically important, microbial diversity is equally, arguably even more, vital to ecosystem stability. Industrial agriculture, habitat destruction, overuse of antibiotics and pesticides, and pollution are all actively degrading microbial communities both in the environment and inside our bodies. The consequences are only beginning to be understood.
Some researchers are drawing alarming connections between the decline of gut microbiome diversity in people living in industrialized societies and rising rates of autoimmune diseases, allergies, and metabolic disorders. The comparison to what’s happening in soils and oceans is striking. When you strip away microbial diversity, systems that once operated with quiet resilience start becoming fragile and unpredictable.
We are, in a sense, dismantling biological infrastructure we don’t fully understand yet, which is a sobering thought.
The Future: Harnessing Microbes for a Healthier Planet
Science is increasingly turning to microbes as solutions rather than problems. Microbial biotechnology is already being used to clean up oil spills, break down plastic waste, develop new antibiotics, produce biofuels, and engineer more drought-resistant crops. The potential feels genuinely limitless, and that’s not an exaggeration for once.
Personalized medicine is another frontier where the microbiome is becoming central. Tailoring treatments to an individual’s specific microbial profile, or using carefully designed microbial therapies to treat conditions like depression, Crohn’s disease, or even cancer, is moving from speculative science fiction into credible research. Fecal microbiota transplants, as unconventional as they sound, have already shown remarkable success in treating recurrent gut infections.
The more we invest in understanding the microbial world, the more we realize we’ve been overlooking a treasure chest that was sitting right under our feet, and inside us, all along.
Conclusion

Microbes are not the enemy. They never were. They are the original architects of life on Earth, the silent partners in every ecosystem, and the invisible caretakers of our own bodies. Respecting and preserving microbial diversity is not just a matter of environmental concern. It’s a matter of human health, food security, and planetary survival.
The more science reveals about these extraordinary organisms, the harder it becomes to justify treating them as background noise. They are the foreground. Everything else, including us, is built on what they do. What surprises you most about the microbial world? Tell us in the comments.



